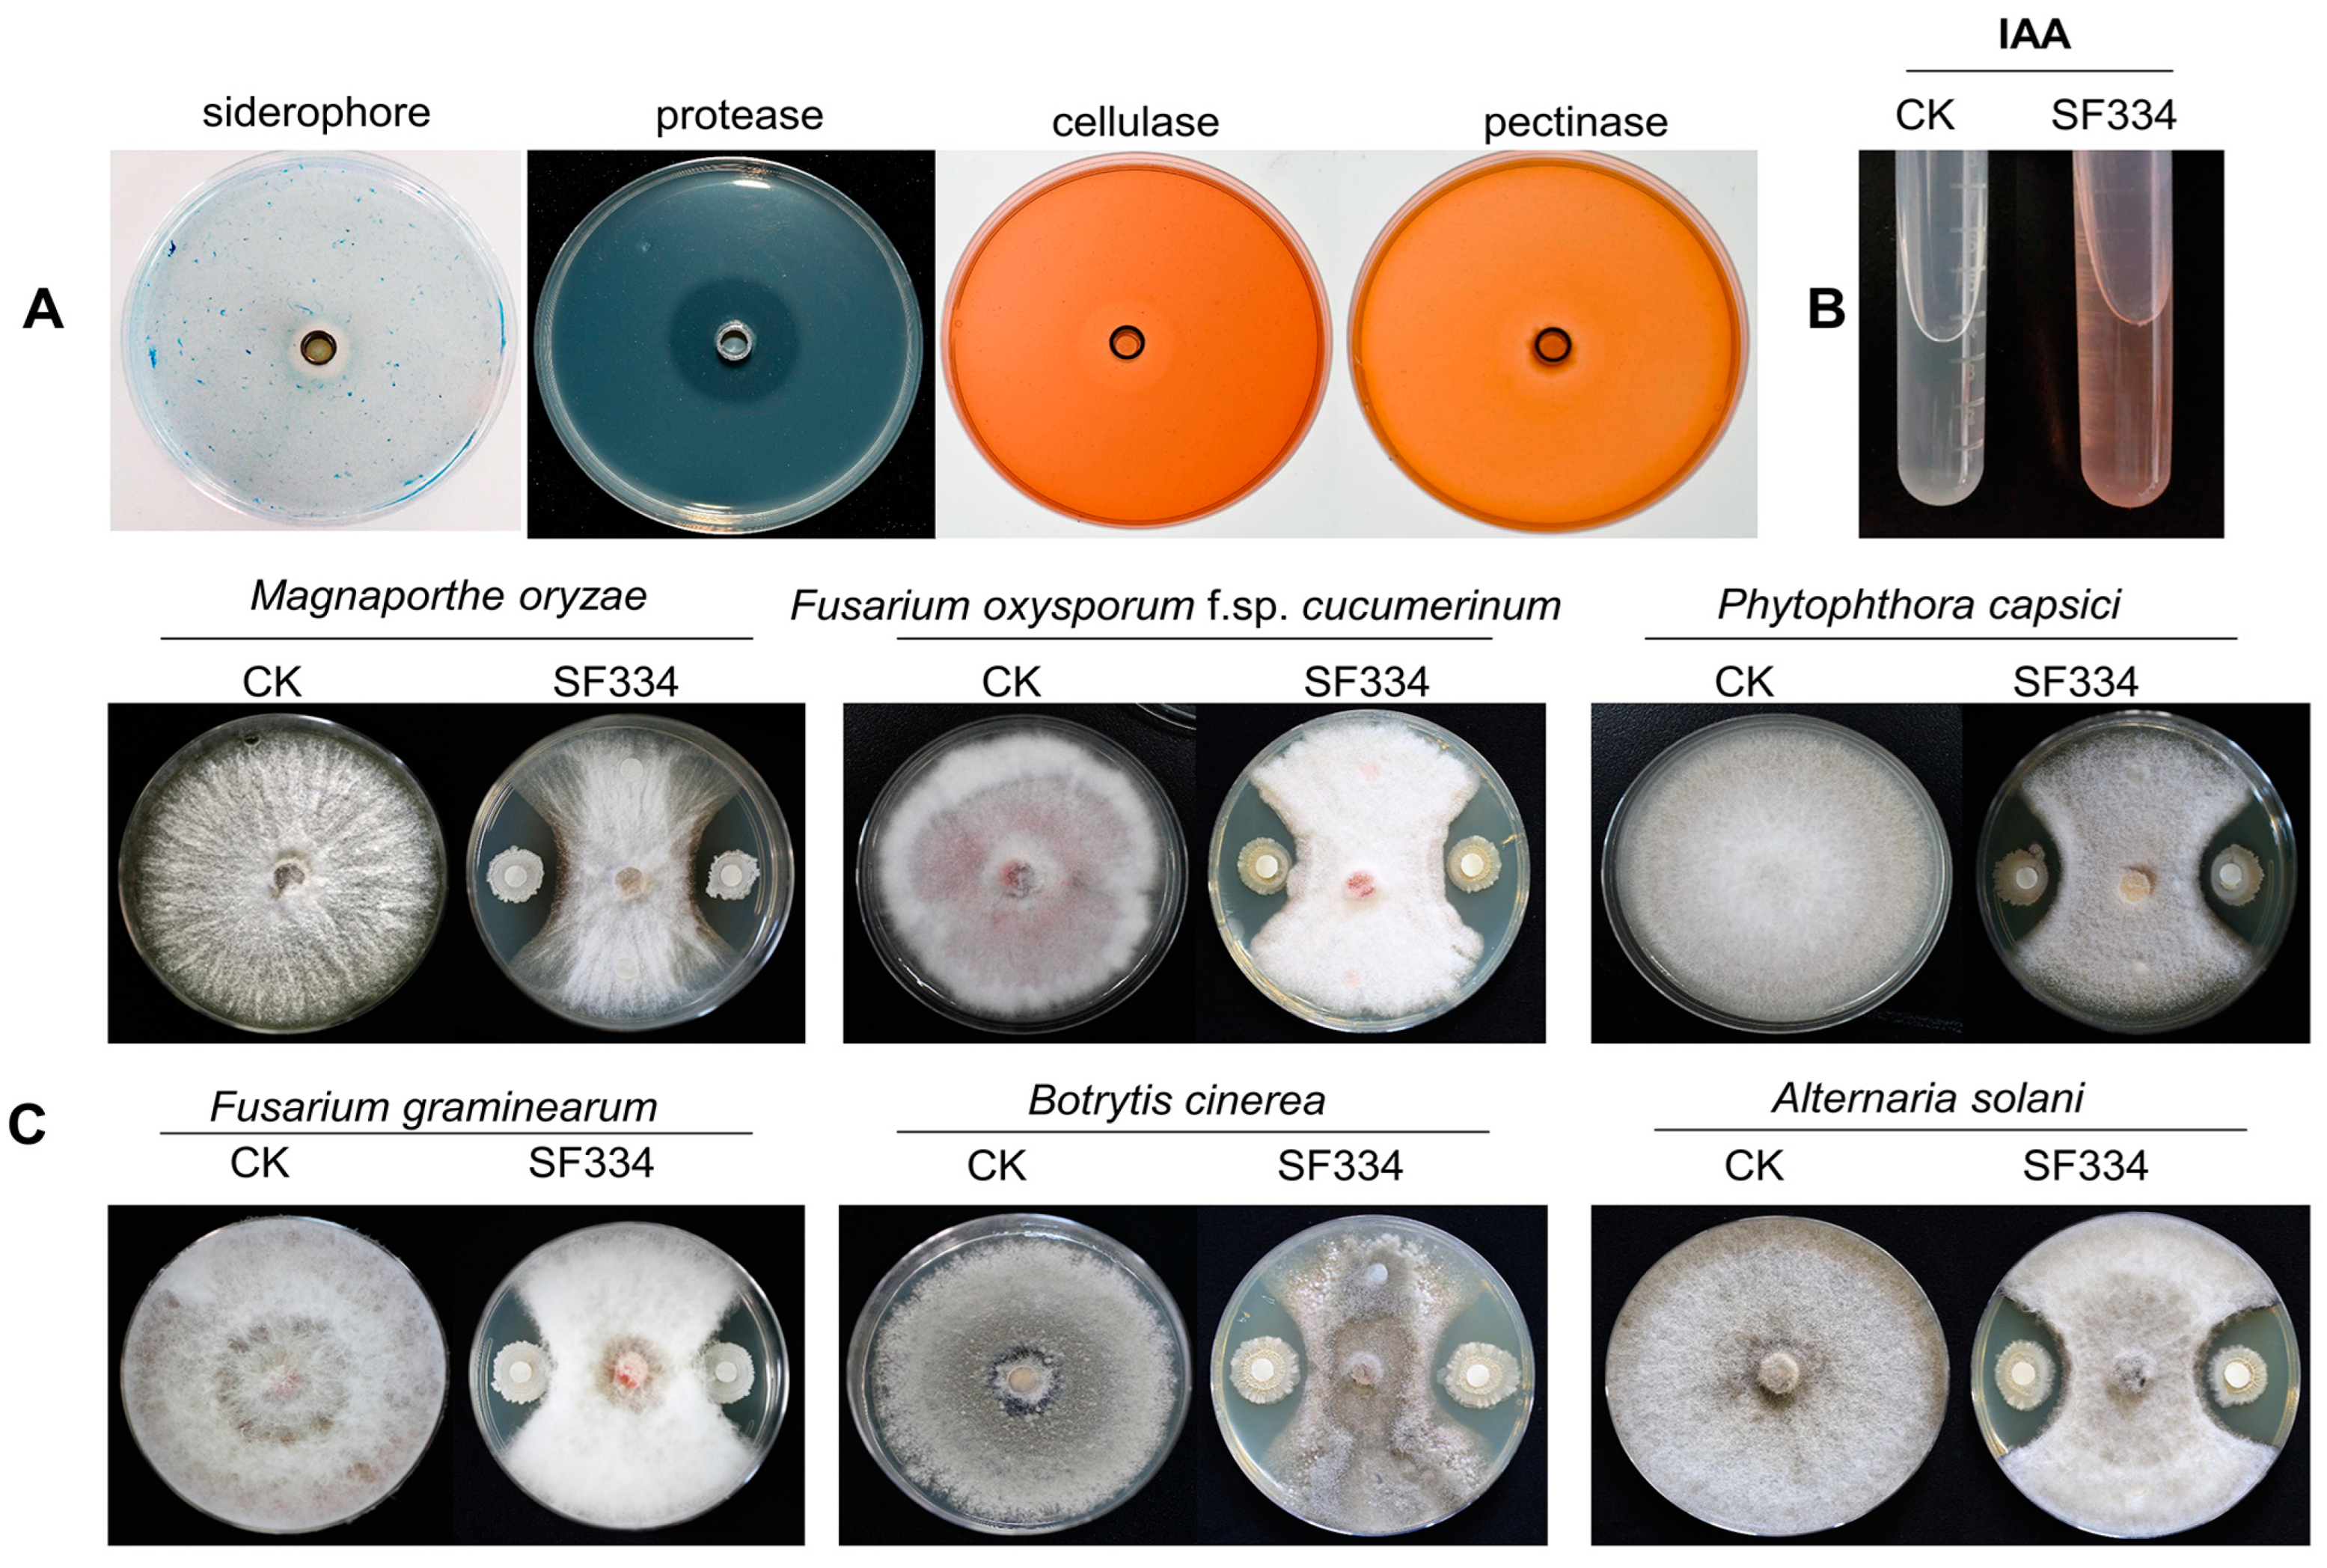
Jof 10 00158 g007 Jof 10 00158 g007

Abstract
Natural rubber is an important national strategic and industrial raw material. The leaf anthracnose of rubber trees caused by the Colletotrichum species is one of the important factors restricting the yields of natural rubber. In this study, we isolated and identified strain Bacillus velezensis SF334, which exhibited significant antagonistic activity against both C. australisinense and C. siamense, the dominant species of Colletotrichum causing rubber tree leaf anthracnose in the Hainan province of China, from a pool of 223 bacterial strains. The cell suspensions of SF334 had a significant prevention effect for the leaf anthracnose of rubber trees, with an efficacy of 79.67% against C. siamense and 71.8% against C. australisinense. We demonstrated that SF334 can lead to the lysis of C. australisinense and C. siamense mycelia by causing mycelial expansion, resulting in mycelial rupture and subsequent death. B. velezensis SF334 also harbors some plant probiotic traits, such as secreting siderophore, protease, cellulase, pectinase, and the auxin of indole-3-acetic acid (IAA), and it has broad-spectrum antifungal activity against some important plant pathogenic fungi. The genome combined with comparative genomic analyses indicated that SF334 possesses most genes of the central metabolic and gene clusters of secondary metabolites in B. velezensis strains. To our knowledge, this is the first time a Bacillus velezensis strain has been reported as a promising biocontrol agent against the leaf anthracnose of rubber trees caused by C. siamense and C. australisinense. The results suggest that B. velezensis could be a potential candidate agent for the leaf anthracnose of rubber trees.
1. Introduction
The rubber tree (Hevea brasiliensis) is a perennial tropical tree that is the primary source of natural rubber, an important industrial raw material [1]. The anthracnose of rubber trees caused by the genus Colletotrichum is one of the main diseases restricting rubber output [2]. The disease mostly affects the leaves, stems, and fruits, causing leaf shedding, stem spotting, branch drying, and fruit rot and eventually resulting in reduced yields of rubber trees [3]. Currently, the disease has been reported to occur in several countries, including Sri Lanka, China [4], India [5], and Brazil [6], and C. gloeosporioides and C. acutatum were considered to be the main causative agents [7]. In recent years, researchers have gradually discovered and identified some new and dominant species. For instance, C. acutatum and C. gloeosporioides causing anthracnose in rubber trees were recorded for the first time in India [8]. Four novel pathogenic species of C. laticiphilum, C. nymphaeae, C. citri, and C. simmondsii, all belonging to the C. acutatum complex, were found in Sri Lanka [9]. C. siamense [10], C. australisinense [10], C. wanningense [7], and C. cliviae [11], which can cause leaf anthracnose in rubber trees, were found in China. C. siamense and C. australisinense are thought to be the main causal species of anthracnose in Hainan province, which is one of the main rubber tree-growing areas in China [10]. The classification of species complexes associated with the anthracnose of rubber trees is complicated, and dominant species in different regions have great differences [3], which introduces certain difficulties to disease control; therefore, the development of effective control measures has become a key priority.
The control of anthracnose-causing rubber trees mainly focuses on chemical, agricultural, and biological controls and breeding for disease resistance. Generally, chemical controls are effective, but they also cause some problems such as environmental pollution and the emergence of drug resistance. Disease-resistant breeding is economical and effective but requires a long research and development process [12]. Agricultural strategies focus on land management and environmental improvement [6], which are economical but slow in effect and have geographical and seasonal characteristics. In contrast, biological controls have brighter application prospects due to the advantages of strong selectivity and environmental friendliness [13]. Some antagonistic strains derived from bacterial and fungal sources were effective in controlling the anthracnose of rubber trees. Three strains of Streptomyces YQ-33, QZ-9, and WZ-2 with high antagonistic activity against C. siamense were isolated and identified [14]. The lipopeptide produced by Bacillus subtilis Czk1 could significantly control the anthracnose of rubber trees [15], and it was more effective when combined with “Rootcon” [16], a common chemical antiseptic. An endophytic fungal strain Epicoccum dendrobii SMEL1 from a young healthy branch of Chinese fir (Cunninghamia lanceolata) was found to have a highly antagonistic effect on C. gloeosporioides [17]. Therefore, the identification of novel antagonistic strains against species of Colletotrichum will provide more microbial resources for the biological control of anthracnose-causing rubber trees.
This study aims to identify the biocontrol strain that has an effective control effect on the leaf anthracnose of rubber trees in the Hainan province of China. In this study, we obtained a Bacillus velezensis strain SF334 that exhibited significant antagonistic activity against both C. australisinense and C. siamense, two major pathogens causing leaf anthracnose of rubber trees in the Hainan province of China, from 69 candidate strains from a pool of 223 bacterial strains using the paper filtering method. SF334 exhibited a great biocontrol potential in the prevention of leaf anthracnose in rubber trees. We explored the mechanism of SF334 inhibiting the mycelial growth of C. australisinense and C. siamense and analyzed the plant probiotic characterizations and antagonistic spectrum of SF334. In addition, we completed whole genome sequencing and conducted the comparative genomic analysis of SF334 with its closely related B. velezensis strains. It was indicated that SF334 has genes associated with antimicrobial and plant growth promotion. These works provided a new microbial resource for the biological control of the leaf anthracnose of rubber trees and laid a preliminary foundation for subsequent applications in forests and fields.
2. Materials and Methods
2.1. Strains and Growth Conditions
All bacterial strains were cultured in nutrient agar (NA, 5 g polypeptone, 10 g sucrose, 1 g yeast extract, 3 g beef extract, 15 g agar, 1000 mL distilled water, pH: 7.0), nutrient broth (NB, NA without agar), or Lysogeny broth (LB) medium at 28 °C. The fungal pathogens causing the leaf anthracnose of rubber trees, C. siamense CS-DZ-1 and C. australisinense CA-DZ-5, were isolated from experimental fields at the National Rubber Germplasm Repository in Hainan, and they were grown on potato dextrose agar (PDA) or in PDB (PDA without agar) medium at 25 °C. Other fungal strains, including Magnaporthe oryzae causing rice blast, Fusarium oxysporum f. sp. Spcucumerinum causing root rot disease of cucumber, F. graminearum causing fusarium head blight, Alternaria solani causing early blight of potato, Phytophthora capsici causing pepper phytophthora blight, and Botrytis cinerea causing gray mold disease of vegetables, were cultured on PDA medium at 25 °C.
2.2. Screening and Identification of the SF334 Strain
A library that includes 223 bacterial isolates has been established in our previous work [18]. C. siamense CS-DZ-1 and C. australisinense CA-DZ-5 were used to screen antagonistic strains. The fungal piece was placed in the center of the PDA media, and the filter papers were placed 2 cm away from the center. In total, 5 μL of the bacterial solution (OD600 = 2.0) was added to the filter papers located in the left and right direction, and the same volume of NB medium was added to the top and bottom as a negative control. Three replicates in each group were cultured at 28 °C for 5–7 days. The inhibition rates were calculated according to the growth diameters, and SF334 with strong antagonistic activity against both C. siamense and C. australisinense was screened. SF334 was isolated from the orchard soil sample collected from Haidian Harbor Garden in Haikou City of Hainan province, China, on 8 November 2018.
The 16S rRNA sequence of SF334 was amplified using the universal primers of 27F and 1492R according to our previous protocol [19]. The sequence was used for searches in the National Center for Biotechnology Information (NCBI) database, and the sequences of the 16s rRNA of 39 strains with the lowest E-value were selected as the reference sequences. The results were finally imported into MEGA 11 software to construct a phylogenetic tree using the NJ (1200 bootstrap) method. Genome-wide phylogenetic trees were constructed using the TYGS platform (https://tygs.dsmz.de/, accessed on 15 May 2023). Average nucleotide identity (ANIb) and DNA-DNA hybridization (DDH) analyses were performed through online websites http://jspecies.ribohost.com/jspeciesws/, accessed on 15 May 2023 and https://ggdc.dsmz.de/, accessed on 15 May 2023, respectively.
2.3. Genomic Sequencing, Assembly, and Annotation of SF334
A single colony of SF334 was inoculated in NB medium and incubated overnight at 28 °C, 200 rpm min−1. The resulting bacterial solution was transferred to a new NB medium at a ratio of 1:100 for further incubation until the liquid reached the logarithmic stage (OD600 is between 0.4 and 0.8). The bacterial solution of SF334 was centrifuged at 4 °C, 6000 rpm min−1 for 10 min and collected, then washed with 1 × PBS buffer twice, and finally removed the supernatant. The resulting bacterial precipitates were frozen in liquid nitrogen for 15 min and then sent to the Beijing Genomics Institute for whole genome sequencing through the PacBio Sequel II platform 4.
After obtaining raw data, low-quality sequences, joint sequences, etc., were removed. Genome assembly was performed by Personalbio (Shanghai, China). Open reading frames were predicted using GeneMark S (http://exon.gatech.edu/GeneMark/, accessed on 1 May 2023); non-coding RNAs were predicted using tRNAscan-SE v1.3.3, Barrnap, and Rfam databases; tandem repeats were predicted using the Tandem Repeats Finder. The assembled sequences were annotated in GO (Gene Ontology), KEGG (Kyoto Encyclopedia of Genes and Genomes), COG (Clusters of Orthologous Groups), Swiss-Prot, NR (Non-Redundant Protein Database), TCDB (Transporter Classification Database), CAZy (Carbohydrate-Active enZYmes Database), CARD (The Comprehensive Antibiotic Resistance Database), antiSMASH, and signal P6.0 databases for functional gene analysis and annotation.
The complete genome sequence of B. velezensis SF334 was deposited in GenBank under accession number CP125289.
2.4. Comparative Genomic Analysis
The genomic features of SF334 and the model strains B. velezensis FZB42, B. velezensis SQR9, B. amyloliquefaciens DSM7, and B. subtilis 168 were compared using the GeneMark (http://exon.gatech.edu/GeneMark/, accessed on 25 May 2023) and RAST (https://rast.nmpdr.org/, accessed on 25 May 2023) databases, and genomics covariance analysis was performed using the Mauve (https://darlinglab.org/mauve/mauve.html, accessed on 25 May 2023) database. Pan-genomic analysis was performed using the BPGA (v.1.3) (https://iicb.res.in/bpga/index.html, accessed on 25 May 2023) tool. The comparative analysis of carbohydrate-active enzymes was carried out using dbCAN2, an online annotation tool available at http://bcb.unl.edu/dbCAN2/, accessed on 25 May 2023, and secondary metabolite gene cluster synthesis was conducted using the online antiSMASH software (https://antismash.secondarymetabolites.org/, accessed on 20 October 2023).
2.5. Biocontrol Assays
For in vitro biocontrol assays, a total of 36 leaves from 1-m-high Brazilian rubber trees that were obtained from the sprout of the “RRIM600” cultivar were inoculated with an agar disk containing the mycelium of C. siamense and C. australisinense. Six agar disks were inoculated on each leaf and cultured at 28 °C for 72 h. The diameters of the lesions were measured. Similar experiments were conducted on live Brazilian rubber trees using the 106 conidium mL−1 suspension of C. siamense and C. australisinense. The SF334 treatment (Tre) strategy meant that leaves were sprayed with the cell suspensions (CSs) of SF334 (OD600 = 1.0) 24 h after inoculation with C. siamense and C. australisinense. The SF334 preventive (Pre) strategy indicated that leaves were sprayed with the CSs of SF334 24 h before inoculation with C. siamense and C. australisinense. The inhibitory percentages (IPs) were calculated using the following formula: IP = (1 − diameters of treatment/diameters of control) × 100%. The IP was calculated using 36 technical replicates per assay.
2.6. Hyphal Digestion Observations
Three bacterial solutions, with each measuring 50 μL of SF334 with different concentrations (OD600 = 1.0, 2.0, and 4.0), were dropped on the PDA medium covered with the mycelium of C. siamense and C. australisinense at a distance of about two centimeters away from the center, and the same volume of NB medium was added to the top as a negative control. The degradation condition of the mycelium was photographed every 30 min.
2.7. Microscopic Observations
The fungal pieces of C. siamense and C. australisinense were added to PDB media, and they were cultured at 28 °C and 180 rpm/min for 2 days; then, they were mixed with the bacterial solution of SF334 (OD600 = 1.5) for further incubation. The samples from the mixture at 1 h postincubation (hpi), 3 hpi, and 6 hpi were stained with 0.05% Evans blue for 2 h; then, they were observed under an optical microscope. The same experiments were conducted as above using the cell-free supernatants (CFSs) of SF334 prepared from the bacterial solution of OD600 = 1.5.
The samples at 1 hpi and 6 hpi were chosen for observation via a scanning electron microscope (SEM). First, the samples were treated overnight with 2.5% glutaraldehyde, and they were fixed by 1% osmium acid. Then, they were dehydrated using 30% ethanol, 50% ethanol, 70% ethanol, 90% ethanol, and anhydrous ethanol in turn. Finally, they were dried using a CO2 critical point dryer. The samples were observed using SEM (NOVA NanoSEM 230) at the Instrumental Analysis Center, Shanghai Jiao Tong University.
2.8. Analysis of Plant Probiotic Characteristics
The cellulase assay medium (20 g carboxymethyl cellulose, 2 g K2HPO4, 0.5 g KH2PO4, 2 g (NH4)2SO4, 6 g NaCl, 0.1 g CaCl2, 0.1 g MgSO4·7H2O, 20 g agar, 1000 mL distilled water, pH 7.0-7.5); chitinase assay medium (15 g chitin colloid, 1.36 g KH2PO4, 1 g (NH4)2SO4, 0.3 g MgSO4·5H2O, 3 g yeast extract, 15 g agar, 1000 mL distilled water, pH 7.0); protease assay medium (A solution: 10% defatted milk, B solution: 3% agar solution; C solution: 0.2 M phosphate buffer, pH = 7.0, A, B, and C were fully mixed); PKO medium (0.5 g (NH4)2SO4, 0.2 g KC1, 0.2 g NaC1, 4 g Ca2(PO4)3, 0.1 g MgSO4·7H2O, 0.0004 g MnSO4, 0.0002 g F eSO4, 0.5 g yeast extract, 10 g sucrose, 15 g agar, 1000 mL distilled water, pH: 7.0); potassium-solubilizing medium (1 g potassium feldspar powder, 1 g CaCO3, 2 g Na2HPO4, 1 g (NH4)2SO4, 0.5 g MgSO4·7H2O:, 10 g sucrose, 0.5 g yeast extract, 15 g agar, 1000 mL distilled water, pH: 7.0); ferritin secretion capacity assay medium (3 g casein acids hydrolysate: 1 mL 1 mM CaCl2, 20 mL 1 mM MgSO4, 50 mL CAS A solution (1 mM CAS, 4 mM HDTMA, 0.1 mM FeCl3); and 5 mL CAS B solution (0.1 mM phosphate buffer, pH = 7.0), 2 g sucrose, 20 g agar, 1000 mL distilled water) were prepared for the analyses of cellulase activity, pectinase activity, protease activity, phosphorus solubilizing activity, potassium solubilizing activity, and siderophore production, respectively. A 50 μL bacterial solution of SF334 (OD600 = 2.0) was filled into an Oxford cup located in the middle of the plate, and the plate was incubated at 28 °C for 48 h to observe whether the hydrolysis circle was produced. If a hydrolytic halo is generated, it indicates that the corresponding enzymatic reaction has occurred, and SF334 has the corresponding enzymatic activity.
For IAA analysis, the bacterial solution of SF334 was directly inoculated into the YM medium (5 g mannitol, 0.05 g NaCl, 0.25 g K2HPO4, 1.5 g yeast extract, 0.05 g L-tryptophan, pH 7.0, 1000 mL distilled water) and then incubated at 28 °C and 135 rpm min−1 for 96 h. The supernatant was mixed with the colorimetric solution (1.5 mL 0.5 M FeCl3, 30 mL H2SO4, 50 mL distilled water) in a 1:1 volume ratio to observe the color changes. If the solution appears pink, the solution contains indolic compounds. The IAA concentration was calculated according to the standard curve formula y = 0.0157x + 0.1137, where Y is the measured UV absorbance in OD530 and X is the IAA concentration value.
2.9. Antifungal Activity Assays
M. oryzae causing rice blast, F. oxysporum f. sp. spcucumerinum causing root rot disease of cucumber, F. graminearum causing fusarium head blight, A. solani causing early blight of potato, P. capsici causing pepper phytophthora blight, and B. cinerea causing gray mold disease of vegetables were used as the target pathogens. The antifungal activity of SF334 was measured using our previous protocol [20].
3. Results
3.1. Screening and Identification of Strain SF334 That Exhibits Highly Antagonistic Activity against C. siamense and C. australisinense
To screen the antagonistic strains of C. siamense and C. australisinense, which are major pathogens causing the leaf anthracnose of rubber trees in the Hainan province of China, we obtained 69 candidate strains from a pool of 223 bacterial strains using the filtering paper method. Among these strains, we found a strain designated as SF334 that exhibited significant antagonistic activity against both C. siamense strain CS-DZ-1 and C. australisinense stain CA-DZ-5 with an average inhibition rate of 66.17% and 68.15%, respectively (Figure 1A and Supplementary Figure S1).

Figure 1.
Screening and identification of strain SF334 that exhibits antagonistic activity against C. siamense and C. australisinense. (A) Antagonistic activity of strain SF334 against C. siamense and C. australisinense, which are major pathogens causing leaf anthracnose of rubber trees in the Hainan province of China. The average inhibition rates of SF334 against C. siamense and C. australisinense were indicated on the plates. (B) The genome features of strain SF334. The outer to inner circles, respectively, indicate genome side (1), forward strands, (2) and reverse strands (3) colored according to the cluster of orthologous group (COG) category, sense strand non-coding RNAs (4), anti-sense strand non-coding RNAs (5), repeat sequence region (6), the GC content (7), and the GC skew in green (+) and purple (−) (8), respectively. (C) The ANIb and DDH values of SF334 with 13 Bacillus strains including 5 strains of B. velezensis.
To clarify the taxonomic status of SF334, we carried out the sequence alignment analysis of the 16S rRNA gene and constructed the corresponding phylogenetic tree (1200 bootstrap). The results indicated 99.94% homology between SF334 and Bacillus velezensis FZB42, a model strain of B. velezensis [21], and the phylogenetic tree showed that SF334 and B. velezensis FZB42 were in the same branch (Supplementary Figure S2), tentatively confirming that SF334 is B. velezensis. We further sequenced the whole genome of SF334 (Figure 1B) and subsequently selected 13 Bacillus strains, including 5 strains of B. velezensis for ANIb and DDH analyses. The ANIb values of SF334 with 5 strains of B. velezensis exceeded 95%, the threshold for species demarcation, and the DDH values also exceeded the accepted species threshold of 70% (Figure 1C). The ANIb and DDH values did not go above the critical classification value for species when SF334 is involved compared to the other strains (Figure 1C). These results further confirmed that SF334 belongs to B. velezensis.
3.2. Assessment of SF334 as Effective Biocontrol Agent for Leaf Anthracnose of Rubber Tree Caused by C. siamense and C. australisinense
We used SF344 to perform biocontrol tests on Brazilian rubber trees. In the experiments based on detached leaves, we sprayed the cell suspensions (CSs) of SF334 on the in vitro leaves of rubber trees and implemented prevention (Pre) and treatment (Tre) strategies. Compared with the control group (CK), the prevention efficacy of the CSs of SF334 for leaf anthracnose caused by C. siamense was 60.08%, and the control efficacy was 39.74% (Figure 2A,C). The prevention and control effect of the CSs of SF334 for leaf anthracnose caused by C. australisinense was 72.15% and 40.6% (Figure 2B,D), respectively.

Figure 2.
The biocontrol assays of SF334 on Brazilian rubber trees based on detached leaves. The in vitro leaves of Brazilian rubber trees were inoculated with either C. siamense (A) or C. australisinense (B) for 72 h. The biocontrol efficiencies were calculated according to the lesions’ diameters relative to C. siamense (C) or C. australisinense (D). The treatment (Tre) strategy meant that leaves were sprayed with the cell suspensions (CSs) of SF334 (OD600 = 1.0) 24 h after inoculation with either C. siamense or C. australisinense, and the preventive (Pre) strategy indicated that leaves were sprayed with the CSs of SF334 24 h before inoculation with either C. siamense or C. australisinense. The Pre and Tre efficacies are indicated. **** indicates statistically significant differences with p < 0.0001.
Further, we conducted similar experiments on live Brazilian rubber trees and found that the prevention efficacies of the CSs of SF334 for anthracnose caused by C. siamense and C. australisinense were 79.60% and 71.96% (Figure 3A–D), whereas the control efficacies were 39.60% and 40.54% (Figure 3A–D), respectively, which was consistent with the results in vitro. These results suggested that SF334 is an effective biocontrol agent for the protection of rubber trees against leaf anthracnose.

Figure 3.
The biocontrol effect of SF334 on Brazilian rubber trees against leaf anthracnose caused by C. siamense and C. australisinense. (A) Leaf anthracnose was caused by C. siamense. (B) Leaf anthracnose was caused by C. australisinense. (C) The biocontrol efficiencies of SF334 were calculated according to the lesions’ diameters relative to C. siamense. (D) The biocontrol efficiencies of SF334 were calculated according to the lesions’ diameters relative to C. australisinense. The treatment (Tre) strategy meant that leaves were sprayed with the cell suspensions (CSs) of SF334 (OD600 = 1.0) 24 h after inoculation with either C. siamense or C. australisinense, and the preventive (Pre) strategy indicated that leaves were sprayed with the CSs of SF334 24 h before inoculation with either C. siamense or C. australisinense. **** indicates statistically significant differences with p < 0.0001.
3.3. B. velezensis SF334 Inhibits C. siamense and C. australisinense by Disrupting Growth of Mycelium
To further explore the antagonistic mechanism of SF334 against C. siamense and C. australisinense, we attempted to drop the bacterial solution of SF334 into the growing hyphae of C. siamense and C. australisinense on PDA media. The hyphae of both C. siamense and C. australisinense were gradually degraded with the extension of interaction time (Supplementary Figure S3) and were completely disrupted at about 3 h postinteraction (hpi) (Figure 4A). The rate of the hyphal degradation of C. siamense and C. australisinense was generally accelerated with an increase in bacterial concentration; however, the difference was weak when the OD600 of the bacterial concentration of SF334 was either 2.0 or 4.0 (Figure 4A and Supplementary Figure S3), suggesting that the ability of SF334 to cause hyphal degradation may be close to its peak.

Figure 4.
Analysis of the antagonistic mechanism of B. velezensis SF334 against C. siamense and C. australisinense. (A) Observation of the hyphal lysis of C. siamense and C. australisinense when interacting with the CSs of B. velezensis SF334 on PDA plates. The mycelia of C. siamense and C. australisinense were inoculated with the indicated bacterial concentration for 0 h and 3 h. (B) Observation of mycelium morphology of C. siamense and C. australisinense using an optical microscope when interacting with the CSs of B. velezensis SF334 in PDB medium with or without 0.05% Evans blue staining. Scale bar, 10 μm.
The observation via optical microscopy showed that SF334 caused the mycelial expansion of C. siamense and C. australisinense (mainly in the apical part and a few in the middle) (Supplementary Figure S4). Evans blue staining showed that the expanded mycelia were stained blue after interaction with SF334, indicating the death of mycelia (Figure 4B). With the prolongation of interaction time, mycelial expansion became more obvious, and the proportion of mycelial death gradually increased (Figure 4B and Supplementary Figure S4).
Since the mycelia of pathogenic C. siamense and C. australisinense depend on the apex’s growth, the apical expansions severely restrict the growth of mycelia. To further investigate the phenotype of mycelial death, we used scanning electron microscopy to observe the interactions of SF334 with C. siamense and C. australisinense. The observations showed that the mycelia of C. siamense and C. australisinense were regular in shape and full; with normal spore germination, the tip of a single mycelium had a prominent growing point and could grow new mycelium continuously (Figure 5). However, the tips of the mycelia of C. siamense and C. australisinense were deformed and bulbous when interacting with SF334 for 1 h or 6 h (Figure 5). The cell walls of the mycelia shrank, and the contents of cells leaked obviously at 6 hpi (Figure 5). Similar mycelial expansion phenotypes were observed when we used the cell-free supernatants (CFSs) of SF334 to interact with C. siamense (Figure 6A), and when we sprayed the CFSs of SF334 on the live leaves of Brazilian rubber trees (Figure 6B). From these results, we speculated that the extracellular active compounds secreted by SF344 may cause deformations of the mycelium, resulting in mycelial rupture and subsequent death.

Figure 5.
Observation of mycelium morphology of C. siamense and C. australisinense using a scanning electron microscope when interacting with the CSs of B. velezensis SF334 for 1 h and 6 h in PDB medium. Scale bars of 10 μm and 50 μm are indicated.

Figure 6.
The mycelial expansion phenotypes were observed when using the cell-free supernatants (CFSs) of SF334 to interact with C. siamense and when spraying the CFSsof SF334 on the live leaves of Brazilian rubber trees. (A) The inhibitory effect against C. siamense of the cell-free supernatants of SF334. The mycelium of C. siamense on PDA plates (upper) and in PDB medium (lower) with 0.05% Evans blue staining observed using an optical microscope. The PDA plates or PDB medium were mixed with the CFSs of SF334 via the indicated volume ratios. (B) Observation of mycelium morphology of C. siamense and C. australisinense when interacting with the CSs of B. velezensis SF334 for 36 h on live leaves of Brazilian rubber trees using a scanning electron microscope. Scale bars of 20 μm, 30 μm, and 50 μm were indicated.
3.4. Analysis of Plant Probiotic Characterizations and Antagonistic Spectrum of B. velezensis SF334
To further examine the potential of SF334 for biocontrol applications, we conducted analyses of plant probiotic characterizations and the antagonistic spectrum against fungal pathogens. The analyses of some plant probiotic traits showed that SF334 could secrete siderophore and protease (Figure 7A); however, they cannot degrade inorganic phosphorus and potassium (data not shown). SF334 also could produce the auxin of indole-3-acetic acid (IAA) (Figure 7B), which is capable of stimulating plant growth. Our quantitative determination showed that SF334 could produce IAA with 9.45 mg/L. SF334 also could secrete cellulase and pectinase (Figure 7A), indicating that SF334 can degrade the components of cell walls from fungi and oomycetes. Whether the extracellular pectinase is responsible for the observed phenotypes of mycelial digestion remains to be determined. Cellulases can also break plant tissues, which might be beneficial if “good” bacteria are allowed to enter into the plant. The antagonistic experiments based on the filter paper method showed that the inhibition rate of SF334 was 59.63% against Magnaporthe oryzae causing rice blast, 50.93% against Fusarium oxysporum f. sp. spcucumerinum causing the root rot disease of cucumber, 56.67% against F. graminearum causing fusarium head blight, 59.26% against Alternaria solani causing the early blight of potato, 51.48% against Phytophthora capsici causing pepper phytophthora blight, and 61.85% against Botrytis cinerea causing the gray mold disease of vegetables (Figure 7C). These results indicated that B. velezensis SF334 has broad-spectrum antifungal activity and is a versatile plant probiotic bacterium.

Figure 7.
Analyses of plant probiotic characteristics and antifungal activity of B. velezensis SF334. (A) The plant probiotic characteristics of B. velezensis SF334, including siderophore production and protease, cellulase, and pectinase activities, were examined on agar plates. (B) The auxin of indole-3-acetic acid (IAA) production of B. velezensis SF334 was tested in YM medium. (C) The antifungal activities of B. velezensis SF334 against five plant pathogenic fungi were measured on PDA plates. M. oryzae causing rice blast, F. oxysporum f. sp. spcucumerinum causing the root rot disease of cucumber, P. capsici causing pepper phytophthora blight, F. graminearum causing fusarium head blight, B. cinerea causing the gray mold disease of vegetables, and A. solani causing early blight of potato were used as the target pathogens.
3.5. Genomic Features and Functional Gene Analysis of B. velezensis SF334
The genome of SF334 consists of a 4,078,641 bp circular chromosome without plasmids (Figure 1B), with a GC content of 46.5%, and 4,164 protein-coding sequences (CDSs), occupying 88.76% of the total chromosome length. SF334 has 86 tRNA genes, 33 sRNA genes, 9 genes for 5S rRNA, 9 genes for 16S rRNA, and 9 genes for 23S rRNA (Table 1).

Table 1.
General features of the B. velezensis SF334 genome.
The COG annotation results revealed that there are 3022 genes annotated relative to the COG database in SF334 (Table 1), accounting for 72.57% of the number of predicted genes. These genes were annotated relative to 24 COG entries, of which 18 entries had more than 100 annotated genes (Supplementary Figure S5A). The most abundant genes are involved in amino acid transport and metabolism, followed by major functional and transcriptional carbohydrate transport and metabolic processes. SF334 has genes encoding peptidoglycan/xylan/gibberellin deacetylase (COG0726), β-glucanase (COG2273), and β-mannanase (COG4124), which may be associated with the hydrolysis of the fungal cell wall. Besides this, SF334 has two iron carrier transport systems (COG0609 and COG1120) that facilitate competition for iron ions from the environment to achieve competitive antibacterial purposes [22].
The GO annotation results showed that 2376 genes were annotated to the GO database in SF334 (Table 1), accounting for 57.06% of the number of predicted genes. Among them, 1297 genes are involved in cellular processes, followed by metabolic processes, catalytic activity, and binding processes (Supplementary Figure S5B). SF334 has gene functions associated with fungal cell structure hydrolase activity, such as carbohydrate metabolism (GO:0005975), a chitin-binding domain (GO:0008061), and a protease core complex (GO:0005839), predicting that SF334 may inhibit pathogenic fungi through antagonistic effects.
The KEGG analysis showed that SF334 has 2554 genes annotated relative to 42 pathways, accounting for 61.33% of the total number of genes (Supplementary Figure S5C), indicating that SF334 has abundant substance metabolic pathways and can use a variety of substances to meet its own needs, making it well adapted to the environment. In addition, SF334 also has genes associated with growth hormone synthesis, such as trpA, trpB, trpC, and aldh (Supplementary Table S1), and it is assumed that SF334 may use tryptophan as a precursor substance to synthesize indole-3-acetic acid through the indole-3-pyruvate pathway (IPA pathway).
CAZy analysis predicted that SF334 has 200 genes encoding carbohydrate-active enzymes, occupying 2.47% of the total number of genes and containing 59 genes related to carbohydrate synthesis and 141 genes related to hydrolysis (Supplementary Figure S5D). Moreover, the SF334 genome contains 5 cellulose biohydrolases (EC 3.2.1.91), 9 tributylases (EC 3.2.1.14), 6 endoglucanases (EC 3.2.1.4), 15 lysozymes (EC 3.2.1.17), 3 mannanases (EC 3.2.1.78), and other related genes that may enable SF334 to have a strong ability to degrade the fungal cell wall. In addition, SF334 contains genes related to alglucan synthesis (EC 3.2.1.28), which are closely related to the stress resistance of the strain [23].
In summary, these analyses suggest that SF334 may be a multifunctional plant probiotic strain with probiotic and biocontrol properties.
The antiSMASH analysis revealed that a total of 16 gene clusters related to secondary metabolite synthesis were obtained from SF334 (Figure 8 and Table 2), among which 9 known secondary metabolite gene clusters (macrolactin H, bacillaene, bacillomycin-D, fengycin, difficidin, bacillothiazole A, bacillibactin, amylocyclicin, and bacilysin) showed 100% similarity to known secondary metabolite synthesis gene clusters included in the database and another other 2 (surfactin and plantazolicin) reached more than 80% similarity, indicating that SF334 has a high probability of synthesizing these secondary metabolites. Surfactin [24], fengycin [25], difficidin [26], bacilysin [27], and bacillibactin [28] all possess antibacterial and antifungal activities, with antibacterial mechanisms involving direct inhibition, lysis, and competitive effects.

Figure 8.
Secondary metabolite biosynthesis gene clusters of B. velezensis SF334 predicted by AntiSMASH. The active molecules related to the gene cluster (color boxes) and the cluster regions according to Table 2 are indicated above and below the horizontal line, respectively. T3PKS, type III polyketide synthase cluster; NRPS, non-ribosomal peptide synthetase cluster.

Table 2.
Secondary metabolite biosynthesis gene clusters of B. velezensis SF334 predicted by AntiSMASH.
3.6. Comparative Genomic Analysis of B. velezensis SF334 with Other Representative Bacillus Strains
To investigate the differences between SF334 and other genetically related Bacillus species, we selected four currently widely studied bacteria, B. velezensis FZB42, B. velezensis SQR9, B. amyloliquefaciens DSM7, and B. subtilis 168, for comparative analysis with SF334. The genomic characteristics of SF334 and the reference strains showed that the genome size of SF334 is between B. velezensis FZB42 and B. velezensis SQR9 (Supplementary Table S2). The genomic GC content, coding region density, tRNA, rRNA, and the number of repeat regions of SF334 are similar to those of FZB42 (Supplementary Table S2). Further collinearity analysis of SF334, FZB42, and SQR9 showed that the genomes of SF334 are highly similar to those of SQR9 and FZB42, with direct linear correspondence for most genes and gene rearrangements, such as translocations in a few cases (Figure 9A). The genomic similarity between SF334 and SQR9 is higher, indicating closer relativity.

Figure 9.
Comparative genomic analysis of B. velezensis SF334 with four other related Bacillus species. (A) Genome-to-genome alignment of B. velezensis SF334 with B. velezensis FZB42, B. velezensis SQR9, B. amyloliquefaciens DSM7, and B. subtilis 168. Boxes with the same color indicate the syntenic regions. (B) Pan-genomic analysis showing the number of genes of orthologous CDSs that are shared and unique between five strains. (C) Comparison of the secondary metabolite biosynthesis gene clusters of B. velezensis SF334 with B. velezensis FZB42, B. velezensis SQR9, B. amyloliquefaciens DSM7, and B. subtilis 168. The same gene clusters are indicated by the same boxes and lines. T3PKS, type III polyketide synthase cluster; NRPS, non-ribosomal peptide synthetase cluster.
Pan-genomic analysis using BPGA showed that SF334 has 2807 core genes and 352 endemic genes between SF334 and the four reference genomes, with high similarity among the five genomes (Figure 9B). COG annotation results showed that the core genes are mainly distributed in the general functional cluster (R), amino acid transport and metabolism (E), and transcription (K) functional classifications, with the lowest proportion in cell cycle, division, and chromosome assignment (D); endemic genes are mainly distributed in general functional clusters (R), transcription (K), and carbohydrate transport and metabolism (G) (Supplementary Figure S6A). The results of KEGG annotation revealed that the core genes are mainly annotated relative to carbohydrate metabolism and amino acid metabolism pathways, and only core genes are found in transcriptional and environmental adaptation pathways; the unique genes are mainly annotated relative to carbohydrate metabolism and cell membrane transport pathways (Supplementary Figure S6B). Combining the annotation results of COG and KEGG, the five strains have similar amino acid transport metabolic pathways, transcriptional pathways, and environmental adaptation pathways, which indicates functional similarity among strains. Each strain has its specific carbohydrate metabolic pathway and cell membrane transport pathway, suggesting that SF334 may have different functional properties, such as unique carbohydrate-active enzymes.
We conducted the comparative analysis between SF334 and the other four Bacillus species in the secondary metabolic gene clusters. Eight secondary metabolic gene clusters responsible for surfactin, terpenes, bacillaene, fengycin, T3PKS, bacillibactin, and bacilysin are present in all three Bacillus species (Figure 9C). Thirteen of the sixteen secondary metabolite gene clusters in SF334 are present in three B. velezensis strains (Figure 9C). The secondary metabolic gene clusters contained by SF334 are highly similar to FZB42, with only one synthesizing more kijianimicin than FZB42. These results suggest that SF334 may have similar biocontrol functions relative to FZB42 in inhibiting microorganisms, inducing host resistance and promoting plant growth.
4. Discussion
In this study, we isolated and identified a strain of B. velezensis SF334, which had a good prevention effect on the leaf anthracnose of rubber trees caused by C. siamense and C. australisinense. In addition, we explored the antagonistic mechanism of SF344 against C. siamense and C. australisinense using microscopic observation, including scanning electron microscopy under the interaction system between biocontrol bacteria and pathogenic fungi. To our knowledge, this is the first report of a B. velezensis strain as a potential biocontrol agent of the leaf anthracnose of rubber trees caused by C. siamense and C. australisinense, which laid a good foundation for the green control of the leaf anthracnose of rubber trees.
So far, there are few cases of the biological control of anthracnose in rubber trees. However, some B. velezensis strains, for instance, B. velezensis CE100 [29], PW192 [30], and HN-2 [31], have been reported to have a high potential as biocontrol agents for anthracnose diseases caused by C. gloeosporioides. In this study, we tested the control effect of SF334 on the anthracnose of rubber trees by inoculating C. siamense and C. australisinense with the Pre and Tre strategies, respectively, and found that efficacy could reach more than 70% using the Pre strategy, which was significantly higher than that exhibited by the Tre strategy. We speculated that the reason for the low efficacy in the Tre strategy was due to our inoculation method, in which the inoculated mass may have provided a higher fungal initial source, resulting in less effectiveness in the subsequent spraying or application of SF334. In the Pre strategy, SF334, which first existed on the leaves, killed part of the initial sources of fungi and simultaneously blocked or delayed the infection of C. siamense and C. australisinense on the leaves of rubber trees. Another speculation is that in this strategy, SF334 might trigger induced systemic resistance in the rubber trees, as some cyclic lipopeptides (i.e., surfactin, fengycin, bacillomycin-D) and volatile organic compounds (VOCs) from two model strains of B. velezensis FZB42 and SQR9 have been reported to induce resistance in plants [28]. It is possible that surfactin prevents fungal attachment as a surfactant agent. Therefore, the key to the prevention and control of leaf anthracnose lies in the early stage of the disease, when the initial number of fungi is not large. The preventive management of B. velezensis as a biopesticide might have an ideal effect.
In this study, we observed an interesting appearance that SF334 can cause the lysis of hyphae when interacting with C. siamense and C. australisinense. Observations using a microscope and scanning electron microscopy revealed that SF334 caused the swollen structures of mycelium; in particular, circular expansion at the growth point of mycelium is the most obvious. The swollen mycelium can be dyed blue using Evans blue, indicating the death of the mycelium. Similar results were observed when the lipopeptide bacillomycin D, produced by B. velezensis FZB42 and HN-2, was shown to interact with the hyphae of F. graminearum and C. gloeosporioides [31,32], indicating that bacillomycin D can cause damage to the cell wall and membranes, resulting in the leakage of the cytoplasm. Conidia could be observed in the control mycelium, but mycelium expansion after SF334 treatment was much larger than that of raw mycelium. We speculated that mycelium expansion, which may occur at the middle or top of the mycelium, with increased frequency at the top, was caused by bacillomycin D generated by SF334, and it is this enlargement of the apex that inhibits conidial formation. Some studies have also found that biosurfactants (i.e., fengycin A and fengycin B) and VOCs (i.e., 5-nonylamine and 3-methylbutanoic acid) produced by B. velezensis exhibited antifungal activity against C. gloeosporioides, the causal agent of the anthracnose disease of fruit trees [29,30]. We found that SF334 secretes cellulase and chitinase, which can degrade the cell walls of fungi and oomycetes. Whether the malformed mycelium of C. siamense and C. australisinense treated by SF334 is due to bacillomycin D or other biosurfactants, as well as cellulase or chitinase, remains to be further explored. We speculated that this digestion effect may not be due to the action of pectinase, because in our other Bacillus velezensis SF305 (data not shown), it can degrade the mycelia of Ganoderma pseudoferreum, causing the red root disease of rubber trees. When the interaction of SF305 and G. pseudoferreum arrived at 12 h, the morphology of the fungus could not be observed under a scanning electron microscope. However, after the interaction between SF334 and the mycelia of C. australisinense and C. siamense for 12 h, although the hypha dies, the whole form remains intact.
B. velezensis is a versatile plant probiotic Gram-positive bacterium that can produce 13 known bioactive molecules, including cyclic lipopeptides (i.e., surfactin, fengycin, bacillomycin-D, bacillibactin), polyketides (i.e., difficidin, bacillaene, macrolactin, kijanimicin), dipeptide antibiotics (bacilysin), and bacteriocins (i.e., plantazolicin, amylocyclicin); saccharides (butirosin A/B); and a new NRPS (bacillothiazols), as well as VOCs (i.e., acetoin, 2,3-butandiol) [28], which have been reported to exhibit a broad spectrum of antagonistic microbial activity. The antagonism of the model B. velezensis strain FZB42 against Rhizoctonia solani causing the bottom rot disease of lettuce and F. graminearum, a plant pathogenic fungus of wheat and barley, has been reported due to the presence of fengycin and bacillomycin-D [32,33]. Bacilysin and difficidin produced by FZB42 were reported to exert a biocontrol effect against bacterial blight and bacterial leaf streak caused by Xoo and Xoc, respectively [26]. FZB42 was also reported to exert an inhibitory effect against soybean pathogen Phytophthora sojae and pear pathogen Erwinia amylovora due to difficidin production [27,28]. Our comparative genomic analysis showed that SF334 is more closely related to FZB42 than SQR9, possessing nine secondary metabolites gene clusters with 100% similarity relative to the ones of FZB42. In addition, we found that SF334 can secrete protease and siderophore and produce IAA, which can promote plant growth, and it has antagonistic effects on some productively important plant pathogenic fungi (i.e., M. oryzae, B. cinerea, P. capsici, F. graminearum, F. oxysporum f. sp. spcucumerinum), suggesting that SF334 is also a multifunctional plant probiotic bacterium.
5. Conclusions
In summary, we isolated B. velezensis SF334 and demonstrated that it is a potential biocontrol agent for the leaf anthracnose of rubber trees. This study not only found a new biocontrol effect of B. velezensis but also provided ideas for the future green prevention and control of rubber tree diseases in the field.
Supplementary Materials
The following supporting information can be downloaded at https://www.mdpi.com/article/10.3390/jof10020158/s1. Supplementary Figure S1: Antagonistic effect of strain SF334 against C. siamense and C. australisinense, which are major pathogens causing leaf anthracnose of rubber trees in the Hainan province of China. Supplementary Figure S2. The phylogenetic tree of strain SF334 is based on 16S rRNA sequences constructed through the TYGS platform. Supplementary Figure S3. Observation of the hyphal lysis of C. siamense and C. australisinense when interacting with the CSs of B. velezensis SF334 on PDA plates. Supplementary Figure S4. Observation of mycelium morphology of C. siamense and C. australisinense when interacting with the CSs of B. velezensis SF334 for 1 h, 3 h, 6 h, and 12 h in PDB medium using an optical microscope. Supplementary Figure S5. Genomic analysis of B. velezensis SF334. The COG analysis (A), GO analysis (B), KEGG pathway analysis (C), and CAZy annotation (D) of B. velezensis SF334. Supplementary Figure S6. Comparative genomic analysis of B. velezensis SF334 with four other related Bacillus species. The COG analysis (A) and KEGG pathway analysis (B) of B. velezensis SF334 with B. velezensis FZB42, B. velezensis SQR9, B. amyloliquefaciens DSM7, and B. subtilis 168. Supplementary Table S1. The plant growth promotion-associated genes in B. velezensis SF334. Supplementary Table S2. General features of genomes of B. velezensis SF334, B. velezensis FZB42, B. velezensis SQR9, B. amyloliquefaciens DSM7, and B. subtilis 168.
Author Contributions
M.W., Y.Z., M.T. and L.Z. designed the research; Y.L. and G.C. (Gongyou Chen) supervised the study; M.W., Y.Z., X.Z., H.C. and Z.Z. analyzed the data and performed part of the experiments; M.W. and Y.Z. wrote the paper and generated the figures; Y.Y., Z.Z., K.Y. and G.C. (Guanyun Cheng) critically revised the manuscript; M.T. was responsible for funding acquisition. All authors have read and agreed to the published version of the manuscript.
Funding
This work was financially supported by the National Key Research and Development Program of China (2023YFD1200204 to M.T.), Hainan Province Science and Technology Special Fund (ZDYF2021XDNY291 to M.T.), and Special Fund for Hainan Excellent Team “Rubber Genetics and Breeding” (20210203 to M.T.).
Institutional Review Board Statement
This article does not contain any studies with human participants or animals performed by any of the authors.
Informed Consent Statement
Not applicable.
Data Availability Statement
The datasets presented in the study can be found online: https://www.ncbi.nlm.nih.gov/bioproject/PRJNA970529. All other data are provided in this article’s Results section and Supplementary Files.
Conflicts of Interest
The authors declare no conflict of interest.
References
- Zou, Z.; Yang, L.F.; Wang, Z.H.; Yuan, K. Biosynthesis and Regulation of Natural Rubber in Hevea. Plant Physiol. Commun. 2009, 45, 1231–1238. [Google Scholar]
- Brown, A.E.; Soepena, H. Pathogenicity of Colletotrichum acutatum and C. gloeosporioides on leaves of Hevea spp. Mycol. Res. 1994, 98, 264–266. [Google Scholar] [CrossRef]
- Lin, C.H.; Zhang, Y.; Liu, W.B.; Li, X.; Miao, W.G. Research Advances on Colletotrichum Leaf Fall Disease of Rubber Trees in China. Trop. Biol. 2021, 12, 393–402+268. (In Chinese) [Google Scholar]
- Xiujuan, L.; Yetong, Y.; Huaiqiong, L. Identification of Species and Forms of Colletotrichum gloeosporioides in Rubber Growing Regions in South China. Trop. Crops 1987, 1, 93–101. (In Chinese) [Google Scholar]
- Forster, H.; Adaskaveg, J.E. Identification of subpopulations of Colletotrichum acutatum and epidemiology of almond anthracnose in California. Phytopathology 1999, 89, 1056–1065. [Google Scholar] [CrossRef]
- Firmino, A.C.; Magalhães, I.P.; Gomes, M.E.; Fischer, I.H.; Junior, E.J.S.; Furtado, E.L. Monitoring Colletotrichum Colonization and Reproduction in Different Rubber Tree Clones. Plants 2022, 11, 905. [Google Scholar] [CrossRef]
- Cao, X.R.; Xu, X.M.; Che, H.Y.; Jonathan, S.; Luo, D.Q. Three Colletotrichum Species, Including a New Species, are Associated to Leaf Anthracnose of the Rubber Tree in Hainan, China. Plant Dis. 2019, 103, 117–124. [Google Scholar] [CrossRef]
- Thakurdas, S.; Arun, K.; Minimol, R.; Kuruvilla, J.C.; Bindu, R.; Nazeer, M.A. Identification of Colletotrichum acutatum from rubber using random amplified polymorphic DNAs and ribosomal DNA polymorphisms. Mycol. Res. 2002, 106, 215–221. [Google Scholar]
- Hunupolagama, D.M.; Chandrasekharan, N.V.; Wijesundera WS, S.; Kathriarachchi, H.S.; Fernando, T.H.P.S.; Wijesundera, R.L.C. Unveiling Members of Colletotrichum acutatum Species Complex Causing Colletotrichum Leaf Disease of Hevea brasiliensis in Sri Lanka. Curr. Microbiol. 2017, 74, 747–756. [Google Scholar] [CrossRef]
- Liu, X.; Li, B.; Cai, J.; Zheng, X.; Feng, Y.; Huang, G. Colletotrichum Species Causing Anthracnose of Rubber Trees in China. Sci. Rep. 2018, 8, e10435-14. [Google Scholar] [CrossRef]
- Zhang, Y.; Zou, L.J.; Li, P.; Wang, M.; Liang, X. First Report of Colletotrichum cliviae Causing Anthracnose of Rubber Tree in China. Plant Dis. 2021, 105, 4163. [Google Scholar] [CrossRef]
- Cai, Z.Y.; Lin, C.H.; Zhai, L.G.; Cai, J.M.; Li, C.P.; Li, B.X.; Wang, Y.L.; Huang, G.X. Evaluation of the resistance of 46 rubber tree clones to Colletotrichum gloeosporioides. Plant Prot. 2013, 39, 110–115. (In Chinese) [Google Scholar]
- Johan, A.S.; Ingvar, S.; Paul, G.B.; Christer, B.; Mukesh, D.; Paul, A.E.; Hanna, F.; José, F.G.; Dan, F.J.; Mattias, J.; et al. When is it biological control? A framework of definitions, mechanisms, and classifications. J. Pest. Sci. 2021, 94, 665–676. [Google Scholar]
- Wang, J.H.; Wang, R.; Gao, J.; Liu, H.Q.; Tang, W.; Liu, Z.Q.; Li, X.Y. Identification of three Streptomyces strains and their antifungal activity against the rubber anthracnose fungus Colletotrichum siamense. J. Genet. Plant. Pathol. 2023, 89, 67–76. [Google Scholar] [CrossRef]
- Fan, L.Y.; He, C.P.; Zheng, F.C.; Li, Q.J. Inhibition and resistance induction of anthracnose of rubber tree by crude extracts of Bacillus subtilis Czk1 lipopeptides. In Proceedings of the 2014 Annual Meeting of the Chinese Plant Protection Society, Xiamen, China, 6–7 November 2014. (In Chinese). [Google Scholar]
- Xie, L.; He, C.P.; Liang, Y.Q.; Li, R.; Gong, J.L.; Zhai, C.X.; Wu, W.H.; Yi, K.X. Antimicrobial activity of Bacillus subtilis Czk1 compounded with chemical fungicides against Colletotrichum gloeosporioides. South. Agric. 2020, 51, 2480–2487. (In Chinese) [Google Scholar]
- Bian, J.-Y.; Fang, Y.-L.; Song, Q.; Sun, M.-L.; Yang, J.-Y.; Ju, Y.-W.; Li, D.-W.; Huang, L. The Fungal Endophyte Epicoccum dendrobii as a Potential Biocontrol Agent against Colletotrichum gloeosporioides. Phytopathology 2021, 111, 293–303. [Google Scholar] [CrossRef]
- Yang, R.; Li, S.; Li, Y.; Yan, Y.; Fang, Y.; Zou, L.; Chen, G. Bactericidal Effect of Pseudomonas oryziphila sp. nov., a Novel Pseudomonas Species against Xanthomonas oryzae Reduces Disease Severity of Bacterial Leaf Streak of Rice. Front. Microbiol. 2021, 12, 759536. [Google Scholar] [CrossRef]
- Li, S.; Chen, Y.; Yang, R.; Zhang, C.; Liu, Z.; Li, Y.; Chen, T.; Chen, G.; Zou, L. Isolation and identification of a Bacillus velezensis strain against plant pathogenic Xanthomonas spp. Acta Microbiol. Sin. 2019, 59, 1969–1983. [Google Scholar]
- Zhou, Q.; Tu, M.; Fu, X.; Chen, Y.; Wang, M.; Fang, Y.; Yan, Y.; Cheng, G.; Zhang, Y.; Zhu, Z.; et al. Antagonistic transcriptome profile reveals potential mechanisms of action on Xanthomonas oryzae pv. oryzicola by the cell-free supernatants of Bacillus velezensis 504, a versatile plant probiotic bacterium. Front. Cell. Infect. Microbiol. 2023, 13, 1175446. [Google Scholar] [CrossRef]
- Fan, B.; Wang, C.; Song, X.; Ding, X.; Wu, L.; Wu, H.; Gao, X.; Borriss, R. Bacillus velezensis FZB42 in 2018: The Gram-Positive Model Strain for Plant Growth Promotion and Biocontrol. Front. Microbiol. 2018, 9, 2491. [Google Scholar] [CrossRef]
- Kramer, J.; Özkaya, Ö.; Kümmerli, R. Bacterial siderophores in community and host interactions. Nat. Rev. Microbiol. 2019, 18, 152–163. [Google Scholar] [CrossRef]
- Duan, J.; Jiang, W.; Cheng, Z.; Heikkila, J.J.; Glick, B.R. The complete genome sequence of the plant growth-promoting bacterium Pseudomonas sp. UW4. PLoS ONE 2013, 8, e58640. [Google Scholar] [CrossRef]
- Ali, S.A.M.; Sayyed, R.Z.; Mir, M.I.; Khan, M.Y.; Hameeda, B.; Alkhanani, M.F.; Haque, S.; Al Tawaha, A.R.M.; Poczai, P. Induction of Systemic Resistance in Maize and Antibiofilm Activity of Surfactin from Bacillus velezensis MS20. Front. Microbiol. 2022, 13, 879739. [Google Scholar] [CrossRef]
- Hanif, A.; Zhang, F.; Li, P.; Li, C.; Xu, Y.; Zubair, M.; Zhang, M.; Jia, D.; Zhao, X.; Liang, J.; et al. Fengycin Produced by Bacillus amyloliquefaciens FZB42 Inhibits Fusarium graminearum Growth and Mycotoxins Biosynthesis. Toxins 2019, 11, 295. [Google Scholar] [CrossRef]
- Wu, L.; Wu, H.; Chen, L.; Yu, X.; Borriss, R.; Gao, X. Difficidin and bacilysin from Bacillus amyloliquefaciens FZB42 have antibacterial activity against Xanthomonas oryzae rice pathogens. Sci. Rep. 2015, 5, 12975. [Google Scholar] [CrossRef]
- Han, X.; Shen, D.; Xiong, Q.; Bao, B.; Zhang, W.; Dai, T.; Zhao, Y.; Borriss, R.; Fan, B. The Plant-Beneficial Rhizobacterium Bacillus velezensis FZB42 Controls the Soybean Pathogen Phytophthora sojae Due to Bacilysin Production. Appl. Environ. Microbiol. 2021, 87, e0160121. [Google Scholar] [CrossRef]
- Rabbee, M.F.; Ali, M.D.; Choi, J.; Hwang, B.S.; Jeong, S.C.; Baek, K.-H. Bacillus velezensis: A Valuable Member of Bioactive Molecules within Plant Microbiomes. Molecules 2019, 24, 1046. [Google Scholar] [CrossRef]
- Kim, T.Y.; Hwang, S.H.; Noh, J.S.; Cho, J.Y.; Maung, C.E.H. Antifungal Potential of Bacillus velezensis CE 100 for the Control of Different Colletotrichum Species through Isolation of Active Dipeptide, Cyclo-(D-phenylalanyl-D-prolyl). Int. J. Mol. Sci. 2022, 23, 7786. [Google Scholar] [CrossRef] [PubMed]
- Jumpathong, W.; Intra, B.; Euanorasetr, J.; Wanapaisan, P. Biosurfactant-Producing Bacillus velezensis PW192 as an Anti-Fungal Biocontrol Agent against Colletotrichum gloeosporioides and Colletotrichum musae. Microorganisms 2022, 10, 1017. [Google Scholar] [CrossRef] [PubMed]
- Jin, P.; Wang, H.; Tan, Z.; Xuan, Z.; Dahar, G.Y.; Li, Q.X.; Miao, W.; Liu, W. Antifungal mechanism of bacillomycin D from Bacillus velezensis HN-2 against Colletotrichum gloeosporioides Penz. Pestic. Biochem. Physiol. 2020, 163, 102–107. [Google Scholar] [CrossRef] [PubMed]
- Gu, Q.; Yang, Y.; Yuan, Q.; Shi, G.; Wu, L.; Lou, Z.; Huo, R.; Wu, H.; Borriss, R.; Gao, X. Bacillomycin D Produced by Bacillus amyloliquefaciens is involved in the Antagonistic Interaction with the Plant-Pathogenic Fungus Fusarium graminearum. Appl. Environ. Microbiol. 2017, 83, e01075-17. [Google Scholar] [CrossRef] [PubMed]
- Chowdhury, S.P.; Uhl, J.; Grosch, R.; Alqueres, S.; Pittroff, S.; Dietel, K.; Schmitt-Kopplin, P.; Borriss, R.; Hartmann, A. Cyclic Lipopeptides of Bacillus amyloliquefaciens subsp. plantarum Colonizing the Lettuce Rhizosphere Enhance Plant Defense Responses toward the Bottom Rot Pathogen Rhizoctonia solani. Mol. Plant Microbe. Interact. 2015, 28, 984–995. [Google Scholar] [CrossRef] [PubMed]
Disclaimer/Publisher’s Note: The statements, opinions and data contained in all publications are solely those of the individual author(s) and contributor(s) and not of MDPI and/or the editor(s). MDPI and/or the editor(s) disclaim responsibility for any injury to people or property resulting from any ideas, methods, instructions or products referred to in the content. |
© 2024 by the authors. Licensee MDPI, Basel, Switzerland. This article is an open access article distributed under the terms and conditions of the Creative Commons Attribution (CC BY) license (https://creativecommons.org/licenses/by/4.0/).